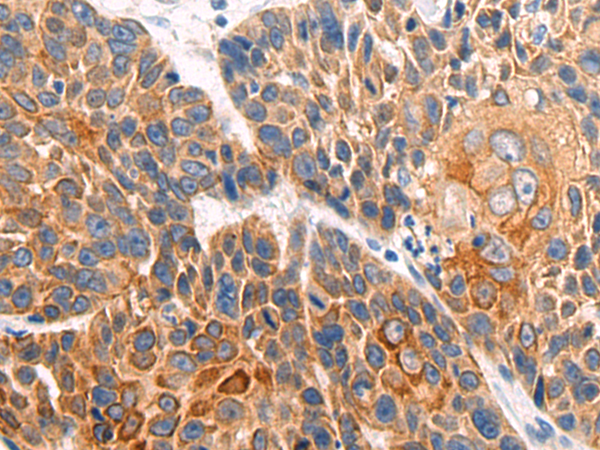
一抗

儲 存: 冷凍(-20℃)
反應(yīng)種屬: Human
標(biāo) 記 物: Unconjugate
克隆類型: rabbit polyclonal
Background:
This gene belongs to the homeobox family of genes. The homeobox genes encode a highly conserved family of transcription factors that play an important role in morphogenesis in all multicellular organisms. Mammals possess four similar homeobox gene clusters, HOXA, HOXB, HOXC and HOXD, located on different chromosomes, consisting of 9 to 11 genes arranged in tandem. This gene is one of several homeobox HOXB genes located in a cluster on chromosome 17.
Applications:
ELISA, IHC
Name of antibody:
HOXB1
Immunogen:
Fusion protein of human HOXB1
Full name:
homeobox B1
Synonyms:
HOX2; HCFP3; HOX2I; Hox-2.9
SwissProt:
P14653
ELISA Recommended dilution:
1000-5000
IHC positive control:
Human cervical cancer and human esophagus cancer
IHC Recommend dilution:
40-150
技術(shù)規(guī)格



 購物車
購物車 幫助
幫助
 021-54845833/15800441009
021-54845833/15800441009